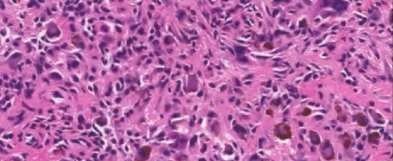
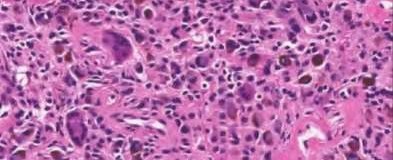

Score: 0%
Orthopedics Online MCQs
ORTHOPEDIC MCQS ONLINE OB HAND 1A
A 35-year-old woman reports wrist pain after a fall onto an outstretched hand. On exam, she has focal tenderness over the wrist snuffbox. A radiograph and CT image are shown in Figures A and B. What is the proper treatment of her injury?













































A 35-year-old woman reports wrist pain after a fall onto an outstretched hand. On exam, she has focal tenderness over the wrist snuffbox. A radiograph and CT image are shown in Figures A and B. What is the proper treatment of her injury?













































Contrast enhanced MRA of the wrist is typically used to diagnose hypothenar hammer syndrome or other vascular abnormalities.
A 20-year-old park ranger trips and falls onto his right wrist with the wrist in extension and pronation. The local urgent care orders both radiographs and a CT, which you review and determine to be normal. The patient complains of ulnar-sided wrist pain. On exam, his tenderness is localized to the fovea. Ulnar deviation also causes him pain. There is no snapping sensation with wrist supination, flexion, and ulnar deviation. He otherwise has 5/5 strength to his first dorsal interosseous muscle with 4mm static two-point discrimination on the ulnar side of the 4th digit. Which of the following injuries is most likely responsible for his symptoms and exam?



























































































































































A 20-year-old park ranger trips and falls onto his right wrist with the wrist in extension and pronation. The local urgent care orders both radiographs and a CT, which you review and determine to be normal. The patient complains of ulnar-sided wrist pain. On exam, his tenderness is localized to the fovea. Ulnar deviation also causes him pain. There is no snapping sensation with wrist supination, flexion, and ulnar deviation. He otherwise has 5/5 strength to his first dorsal interosseous muscle with 4mm static two-point discrimination on the ulnar side of the 4th digit. Which of the following injuries is most likely responsible for his symptoms and exam?

volar tenderness along the flexor sheath
Patients commonly present 24 to 48 hours after onset of symptoms. The standard of care is “urgent surgical drainage” to avoid tendon scarring or necrosis with subsequent impairment of finger function followed by intravenous antibiotic administration.
According to Hand Surgery Update 3, open sheath irrigation has been replaced
largely by closed sheath irrigation. These authors cite a retrospective study that showed no statistical difference in resolution of infection using open sheath irrigation or closed sheath irrigation, however, there was a trend towards more frequent complications and reoperations in the open drainage group.
Lille et al reviewed the records of 75 patients with pyogenic flexor tenosynovitis and found that there was no difference in outcomes between those who received intraoperative irrigation only versus those receiving intraoperative irrigation and continuous postoperative irrigation.
A 50-year-old woman is diagnosed with carpal tunnel syndrome. She is prescribed a cock-up wrist splint at 30 degrees of extension to wear at night. This splint has what effect on the carpal tunnel?















































Patients commonly present 24 to 48 hours after onset of symptoms. The standard of care is “urgent surgical drainage” to avoid tendon scarring or necrosis with subsequent impairment of finger function followed by intravenous antibiotic administration.
According to Hand Surgery Update 3, open sheath irrigation has been replaced
largely by closed sheath irrigation. These authors cite a retrospective study that showed no statistical difference in resolution of infection using open sheath irrigation or closed sheath irrigation, however, there was a trend towards more frequent complications and reoperations in the open drainage group.
Lille et al reviewed the records of 75 patients with pyogenic flexor tenosynovitis and found that there was no difference in outcomes between those who received intraoperative irrigation only versus those receiving intraoperative irrigation and continuous postoperative irrigation.
A 50-year-old woman is diagnosed with carpal tunnel syndrome. She is prescribed a cock-up wrist splint at 30 degrees of extension to wear at night. This splint has what effect on the carpal tunnel?
















































Keywords